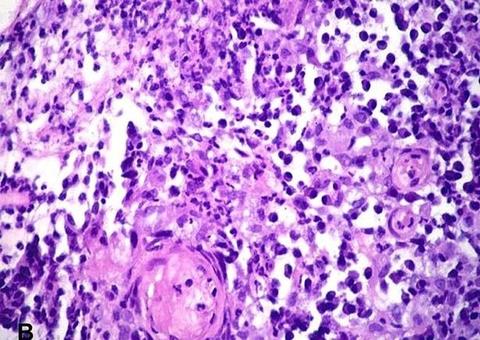
Mulher contrai doença rara que come a pele dos órgãos genitais

Muitas mulheres admiram idolatram a boneca barbie e algumas desejam ser ela. Esse é o caso de Kerry Miles, 34, que já passou por diversas práticas para ficar parecida com a boneca.
Recentemente, a jovem afirmou que vai remover nada menos que 6 costelas para ter a cintura idêntica a Barbie. Ela se submeteu a uma dieta rigorosa e usou uma cinta para diminuir as medidas abdominais, mas isso não foi o suficiente para Kerry.

"Não estou feliz com os resultados, já que a Barbie tem uma cintura bem fina e eu preciso ainda perder alguns centímetros", disse ao "Mirror". A jovem já tem R$ 76 mil para fazer a cirurgia.
Viciada em plásticas, ela já fez rinoplastia e já passou por dois implantes de silicone nos seios. Além disso, Kerry também fez preenchimento nos lábios. "Nunca vou deixar de buscar a perfeição para ficar mais parecida a cada ano", comentou ela.

Aviso